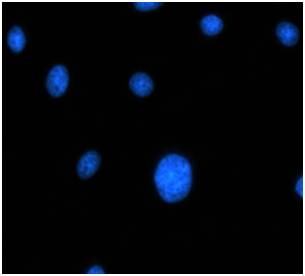

AcquCAM 23G
(Down load Catalog ACQUCAM 23G)
- USB 3.0 Color Camera
- 1/1.2 ” Exmor Sensor
- 1920×1200 pixel
- Trigger input and I/O
The displays live digital images with gradual smoothness and combines exceptional resolution with faithful color reproduction.The new sensors feature a global shutter function and able to capture a high-speed moving image without focal plane distortion. High-speed processing, low noise and low power dissipation by using column-parallel A/D conversion. equipped with trigger mode, and the external pulse can control accumulation time. The Sensor also have a pulse output function to indicate respective conditions during shutter operation and can be coordinated with peripheral circuits. High-definition images can be displayed live at a rate of high frames per second. without compression. Such imaging quality enables even the finest cellular regions to be observed clearly and distinctly without deterioration. While focusing is made stress free.
Universal camera- wide range of image acquisition is available
Setting function of variety color images

Live sharpness adjustment

| Spec | Description |
| Size | 1/1.2 inch |
| Resolution | H: 1920, V: 1200 |
| Pixel size | H: 5.86 µm, V: 5.86 µm |
| Video formats& Frame rate | 1920×1200 RGB32 @ 54 fps1920x1200 Y16 @ 25 fps
1920×1200 Y800 @ 54 fps |
| Dynamic range | 8 / 12 bit |
| Exposure time | 1/100000 to 30 s |
| Lens mount | C/Cs mount |
| Interface | USB 3.0 |
| Power supply | 4.5 to 5.5 VDC |
| Dimensions | H: 29 mm, W: 29 mm, L: 43 mm |
| Mass |
65 g |